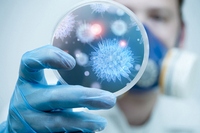
В Ташкенте пройдет международный форум по контролю онкологических заболеваний

14.10.2015
К 2020 году у узбекистанцев появятся электронные медицинские карты международного образца
Электронная медицинская карта или как ее еще называют в народе анкета будет заводиться в поликлинике с момента рождения и вестись пожизненно. Переход на такой формат позволит решить сразу несколько проблем, которые возникают при использовании традиционных бумажных анкет.
14.10.2015
Международный форум по контролю онкологических заболеваний начал свою работу
14 октября 2015 года в Международном бизнес центре открылся «Международный Форум лидеров по контролю онкологических заболеваний в Центральной Азии».
13.10.2015
Реформы в здравоохранении позволили Узбекистану достичь намеченных в Целях развития тысячелетия показателей
В Узбекистане создана современная и эффективная национальная модель здравоохранения, которая базируется на принципах приоритетности социальной защиты населения, создания многопрофильных и специализированных медицинских учреждений, а также прогрессивного повышения качества оказываемых медицинских услуг путем совершенствования диагностики и квалификации медперсонала.
13.10.2015
В Ташкенте пройдет международный форум по контролю онкологических заболеваний
14-16 октября 2015 года в столичном Международном бизнес-центре состоится международный форум по контролю онкологических заболеваний в Центральной Азии.
13.10.2015
Сельские врачебные пункты – на службе у населения
Проводимые под руководством Президента страны последовательные реформы в системе здравоохранения результативно сказываются на охране здоровья населения, укреплении материально-технической базы медицинских учреждений, повышении качества медицинских услуг.
13.10.2015
Объявлен набор для обучения в Республике Корея
Министерство здравоохранения сообщает, что в рамках реализации проекта «Создание детского многопрофильного медицинского центра», предусмотрено обучение специалистов в Республике Корея с возможностью последующего трудоустройства в будущей клинике.
13.10.2015
Правильное питание и здоровье
Уделяемое под руководством Президента Ислама Каримова постоянное внимание охране здоровья человека, пропаганде здорового образа жизни, обеспечению продовольственной безопасности способствует увеличению средней продолжительности жизни населения нашей страны.
12.10.2015
Законодательная система в обеспечение санитарно-эпидемиологического благополучия
12 октября текущего года в Национальном пресс-центре Узбекистана Министерством здравоохранения была организована пресс-конференция на тему “Законодательная система обеспечения санитарно-эпидемиологического благополучия населения, накопленный опыт и приоритетные задачи”.
10.10.2015
Внимание – здоровью детей
В Джизакской области реализуется новый проект по дальнейшему улучшению охраны здоровья детей.
09.10.2015
Недели оздоровления
В столице по инициативе Ташкентского городского главного управления здравоохранения вторая неделя каждого месяца объявлена Неделей оздоровления. Цель организуемой акции – охрана здоровья населения, укрепление в семьях здорового образа жизни, своевременное выявление возникших заболеваний, реализация программ оздоровления.
09.10.2015
Здоровый ребенок – будущее страны
Безгранична роль спорта во всестороннем развитии детей. В связи с этим в нашей стране под руководством Президента Ислама Каримова уделяется особое внимание популяризации спорта среди молодежи, созданию возможностей и условий для занятий детьми спортом.
08.10.2015
Партнерство в деле охраны здоровья матери и ребенка
8 октября 2015 года в Министерстве здравоохранения состоялось заседание Координационного совета по программам охраны здоровья матери и ребенка.
08.10.2015
Об участии Министерства здравоохранения Республики Узбекистан в работе 21-ой Ташкентской Международной Туристской Ярмарки «Туризм на шелковом пути», 5-7 октября 2015 г.
Экспозиция Министерства здравоохранения Республики Узбекистан приняла участие в работе 21-й Ташкентской Международной Туристской Ярмарки «Туризм на Шёлковом пути», которая состоялась 5-7 октября 2015 года в Национальном выставочном комплексе «Узэкспоцентр».
07.10.2015
Мед – панацея от тысячи бед
Особое внимание, уделяемое под руководством Президента нашей страны развитию фермерского движения, расширению заготовок животноводческой, рыбоводческой и пчеловодческой продукции в процессе реформирования сельского хозяйства, способствует насыщению рынков и обеспечению населения качественной и доступной отечественной продовольственной продукцией.
07.10.2015
Сайт Министерства здравоохранения – победитель Национального интернет-конкурса «MIT.uz-2015»
6 октября 2015 года во дворце «Туркистон» состоялась церемония награждения победителей национального интернет-конкурса «MIT.uz».
06.10.2015
Современное медицинское обслуживание на селе
Проводимая под руководством Президента страны работа по укреплению здоровья населения, дальнейшему улучшению качества медицинского обслуживания дает свои высокие результаты. В частности, население довольно услугами 293 сельских врачебных пунктов в Ферганской области.
06.10.2015
Социальной защите – постоянное внимание
Международным благотворительным фондом "Соглом авлод учун" совместно с государственными и общественными организациями, медицинскими и образовательными учреждениями реализуется ряд проектов по социальной защите населения, поддержке людей с ограниченными возможностями.
06.10.2015
Плавание – залог здоровой жизни
Шерзод страдал лишним весом. Появились усталость, одышка. Врачи рекомендовали ему заняться лечебной гимнастикой и плаванием.
03.10.2015
Пожилые люди прошли полную вакцинацию против гепатита В
В рамках Государственной программы «Год внимания и заботы о старшем поколении» на протяжении 9 месяцев текущего года был осуществлен целый ряд практических мер на пути надежной защиты старшего поколения.
03.10.2015
За пробиотиками – будущее
В нашей стране под руководством Президента Ислама Каримова в центре постоянного внимания находится человек, его интересы, в том числе здоровье. В годы независимости была кардинально перестроена система здравоохранения, уделяется огромное внимание дальнейшему развитию и совершенствованию всех направлений медицины, включая микробиологию.